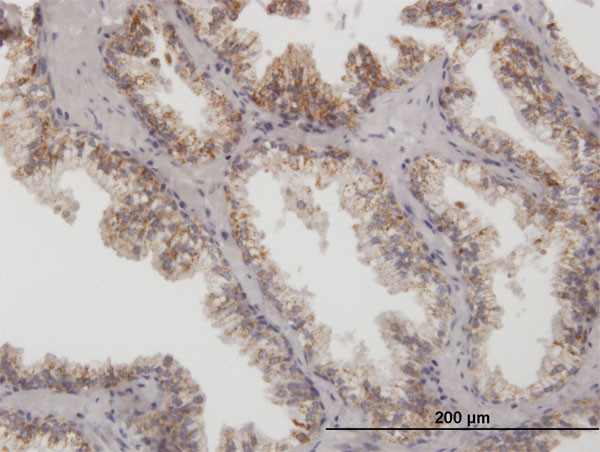
ARG2 Antibody in Immunohistochemistry (Paraffin) (IHC (P))

Search
Abnova
ARG2 Polyclonal Antibody, MaxPab™
{{$productOrderCtrl.translations['antibody.pdp.commerceCard.promotion.promotions']}}
{{$productOrderCtrl.translations['antibody.pdp.commerceCard.promotion.viewpromo']}}
{{$productOrderCtrl.translations['antibody.pdp.commerceCard.promotion.promocode']}}: {{promo.promoCode}} {{promo.promoTitle}} {{promo.promoDescription}}. {{$productOrderCtrl.translations['antibody.pdp.commerceCard.promotion.learnmore']}}
产品信息
H00000384-B01P
宿主/亚型
分类
类型
抗原
偶联物
形式
浓度
规格
保存条件
运输条件
产品详细信息
Sequence of this protein is as follows: MSLRGSLSRL LQTRVHSILK KSVHSVAVIG APFSQGQKRK GVEHGPAAIR EAGLMKRLSS LGCHLKDFGD LSFTPVPKDD LYNNLIVNPR SVGLANQELA EVVSRAVSDG YSCVTLGGDH SLAIGTISGH ARHCPDLCVV WVDAHADINT PLTTSSGNLH GQPVSFLLRE LQDKVPQLPG FSWIKPCISS ASIVYIGLRD VDPPEHFILK NYDIQYFSMR DIDRLGIQKV MERTFDLLIG KRQRPIHLSF DIDAFDPTLA PATGTPVVGG LTYREGMYIA EEIHNTGLLS ALDLVEVNPQ LATSEEEAKT TANLAVDVIA SSFGQTREGG HIVYDQLPTP SSPDESENQA RVRI
靶标信息
Arginase catalyzes the hydrolysis of arginine to ornithine and urea. At least two isoforms of mammalian arginase exists (types I and II) which differ in their tissue distribution, subcellular localization, immunologic crossreactivity and physiologic function. The type II isoform encoded by this gene, is located in the mitochondria and expressed in extra-hepatic tissues, especially kidney. The physiologic role of this isoform is poorly understood; it is thought to play a role in nitric oxide and polyamine metabolism. Transcript variants of the type II gene resulting from the use of alternative polyadenylation sites have been described.
仅用于科研。不用于诊断过程。未经明确授权不得转售。